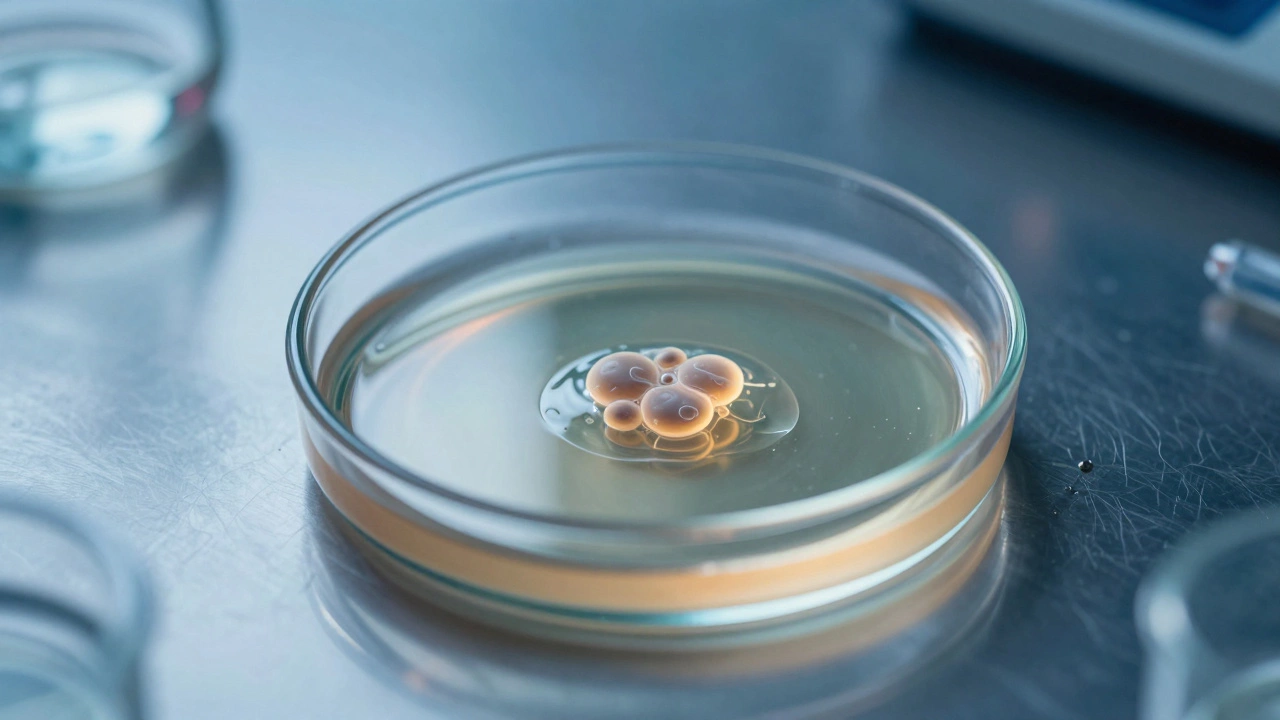
Close up of a human embryo inside a glass petri dish under a microscope

IVF History Explorer
Use the timeline slider below to explore how In Vitro Fertilization (IVF) has evolved from the historic birth of Louise Brown in 1978 to modern advancements in 2026.
Available Technology
Impact & Statistics
When people ask about the most famous baby born through In Vitro Fertilizationis a medical procedure where an egg is fertilized by sperm outside the body, there is only one name that truly stands out above the rest. That person is Louise Joy Brown. Born on July 25, 1978, in Oldham, England, Louise isn't just a celebrity in the traditional sense; she is the face of a medical revolution. For decades, her birth certificate marked the exact moment humanity could finally intervene when natural conception wasn't possible.
The reason she remains the most famous IVF baby lies in the timeline. Before 1978, infertility was often a secret shame. Couples struggled in silence because effective medical treatments didn't exist. When Louise arrived healthy, it proved that eggs and sperm could meet in a petri dish to form life. This concept changed everything. It moved fertility from the realm of hope to the realm of science. While millions have followed in her footsteps, her name defines the starting point.
The Science Behind the Miracle
To understand why Louise Brown is so significant, you have to look at the technology involved. Assisted Reproductive TechnologyARTencompasses various procedures used to help people become pregnant relies on precise biological timing. In natural conception, ovulation releases an egg. If sperm meets that egg in the fallopian tubes, fertilization happens. However, for some women, blockages prevent this meeting. For others, sperm counts are too low.
The breakthrough came from combining two things: ovarian stimulation and embryo transfer. Doctors had to induce multiple eggs to mature using hormones. Then, they had to retrieve those eggs safely. Finally, they needed a sterile environment for fertilization before placing the resulting embryo back into the uterus. Louise Brown's team managed all of this without the digital tools we take for granted today. They did it in an operating room with basic laboratory equipment.
| Feature | Early IVF (1978) | Modern IVF (2026) |
|---|---|---|
| Egg Retrieval Method | Surgical laparoscopy | Ultrasound-guided needle aspiration |
| Fertilization Technique | Conventional mixing | ICSI (Intracytoplasmic Sperm Injection) |
| Success Rate per Cycle | Approximately 28% | Approximately 45-50% |
| Genetic Screening | None available | PGT-A widely used |
The Doctors Who Made It Possible
Louise wouldn't exist without the determination of Professor Robert EdwardsResearcherCo-developer of the IVF technique. He was a biologist obsessed with understanding how human embryos develop. Alongside him was gynecologist Patrick SteptoeGynecologistPerformed surgical retrieval of eggs. Steptoe knew how to operate inside the female body. Edwards knew how to nurture cells in a lab. Together, they formed an unlikely partnership.
They faced immense criticism. Religious groups called their experiments unnatural. The media sometimes labeled Louise a "test tube baby," which implied something artificial rather than human. Many scientists doubted the embryo would survive implantation. They worried about genetic defects or long-term health issues. These fears turned out to be unfounded, but the skepticism highlights how radical the idea was at the time. In 2010, Robert Edwards received the Nobel Prize in Physiology or Medicine for his work. Patrick Steptoe had passed away in 1988, but his legacy remains cemented alongside Edwards.
Louise Brown Today
You might wonder what happened to Louise after the cameras stopped filming. She grew up like any other child. As an adult, she has chosen to keep her distance from the limelight, unlike many celebrities. However, her existence sparked a movement. In 1995, she gave birth to a daughter named Natalie. This was a huge deal. It proved that IVF-conceived individuals could reproduce naturally themselves. The concern that DNA damage might skip generations was debunked.
Natalie Brown went on to give birth to a son as well, confirming that the lineage was biologically robust. There are no known medical issues directly stemming from the IVF process affecting Louise or her family tree. This fact reassured countless couples around the world. It showed that the method was safe for future generations, not just immediate pregnancy outcomes. This generational proof was just as important as the birth itself.
Global Expansion and Other Notable Cases
While Louise holds the title of the first, she isn't alone in history books. Over 10 million babies have been born using assisted techniques globally since 1978. In India, the first successful IVF birth occurred in 1986 at the Aravind Eye Care HospitalChennai Fertility Center ecosystem, though widespread adoption took longer due to infrastructure challenges. Dr. Balwant Singh Rao led early initiatives there, bringing the cost down for local populations compared to Western prices.
Celebrity culture has also played a role in normalizing the treatment. Stars like Cameron Diaz and Rosie Huntington-Whiteley have spoken openly about their struggles. However, these high-profile cases reinforce the narrative started by Louise Brown. They bring visibility to the financial and emotional toll of fertility treatment. When a public figure shares their journey, insurance companies and governments sometimes pay more attention to funding access.
In terms of sheer numbers, countries like the USA and China report the highest volumes of cycles annually. Yet, Europe remains a stronghold for innovation due to strict regulatory frameworks. The European Society of Human Reproduction and Embryology publishes annual registries that track safety metrics. These data points ensure that clinics adhere to standards set by pioneers like Edwards and Steptoe. It keeps the quality of care consistent regardless of geography.
Social and Ethical Evolution
The story of the first IVF baby also changed how society views parenthood. Before this era, childless marriages were often viewed as tragic or incomplete. Now, families are recognized through intention and effort, not just biology. Single mothers by choice and same-sex couples can build families with donor gametes or surrogacy combined with IVF. The door opened by Louise Brown allows for diverse family structures to exist legally and biologically.
This shift brings ethical debates to the forefront. We discuss frozen embryos and ownership rights. Questions arise about selecting for gender or eliminating genetic diseases. Preimplantation Genetic Testing (PGT) now lets us screen embryos for serious disorders. This technology prevents conditions like Tay-Sachs disease. But it also raises slippery slope arguments regarding designer babies. We must navigate these topics carefully as we stand in the shadow of 2026 technologies.

The Current Landscape in 2026
As we move further into the decade, AI is integrating into fertility labs. Algorithms predict which embryos are most likely to implant successfully based on visual analysis. This reduces the number of failed attempts for patients. However, the core principle remains the same as 1978. We still harvest eggs, we still fertilize them externally, and we still place them back into the womb. The fundamentals haven't changed, even if the tools have sharpened.
Cost remains a barrier. While success rates improved to nearly 50% per cycle in some demographics, money is still required. Public funding exists in places like the UK National Health Service, but restrictions often apply based on age or BMI. In private markets, the price tag for a full cycle is steep. Innovations in egg cryopreservation are helping women save fertility potential before medical treatment begins. These options add flexibility to the equation, reducing the pressure of age.
Frequently Asked Questions
Is Louise Brown still alive?
Yes, Louise Brown is alive and living privately in the United Kingdom. She maintains a low profile to avoid media intrusion while leading a normal life as an adult.
How many IVF babies have been born worldwide?
Estimates suggest over 10 million babies have been born via IVF procedures since 1978. Recent data suggests thousands are born daily through these methods.
Are IVF babies born healthy?
Most studies indicate that IVF babies are generally healthy. There may be a slightly higher risk of low birth weight or preterm delivery compared to natural conceptions, but major defects are rare.
Did Louise Brown get married?
Louise Brown has kept her personal relationship status largely out of the public eye. However, she has confirmed she has raised children naturally and lives a family-oriented life.
Who won the Nobel Prize for IVF?
Professor Robert Edwards was awarded the Nobel Prize in Physiology or Medicine in 2010 for developing the technique of IVF. His partner Patrick Steptoe died prior to the award eligibility rules allowing posthumous nominations.
The legacy of the most famous IVF baby extends far beyond a single headline. It reshaped the definition of family and the limits of medical intervention. From a tiny town in Lancashire to laboratories in Bangalore and beyond, that single success created a pathway for hope. Whether you are researching history or planning a future, knowing where we started helps us appreciate where we are going. The journey continues, driven by the same desire to connect a new life with its parents.
